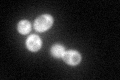
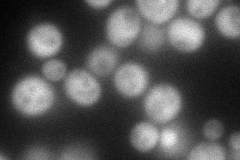
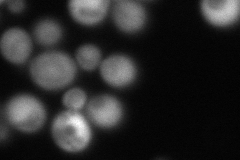
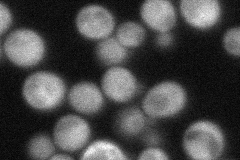
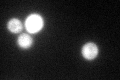

View description
Subunit of the heterohexameric cochaperone prefoldin complex which binds specifically to cytosolic chaperonin and transfers target proteins to it
Localization:
Intensity:
Fold change:
Significance:
-
C’ GFP library in SD
cytosol94.94 -
N' NOP1pr-GFP in SD
cytosol101.52 -
N' TEF2pr-mCherry in SD
cytosol119.195 -
N' NATIVEpr-GFP in SD
cytosol51.5352 -
N' TEF2pr-VC and Cyto-VN in SD

#N/A0 -
C’ GFP library in SD+DTT
cytosol89.320.94No -
C’ GFP library in SD+H2O2

cytosol63.720.67No -
C’ GFP library in Starvation Media

cytosol73.840.77No -
C’ GFP library on the background of Pup2-DaMP

cytosol -
C’ GFP library on the background of CCT mutant

cytosol79.40490.836287No
